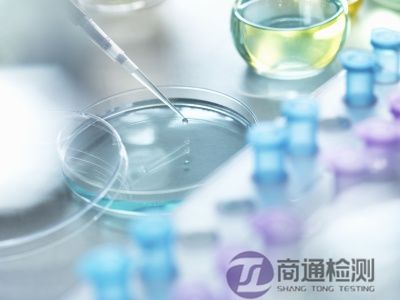
EN 61010-1儀器設備

EN 61010-1 是歐洲針對測量、控制和實驗室電氣設備的安全標準,在 CE 認證中,是確保儀器設備符合電氣安全要求的重要依據。
一、EN 61010-1儀器設備標準概述
1. 適用范圍
實驗室設備:分析儀器、離心機、光譜儀等。
工業測量設備:傳感器、測試儀器、過程控制設備。
醫療關聯設備:體外診斷(IVD)設備的電氣安全部分(需結合EN 61010-2-101)。
排除范圍:家用電器(適用EN 60335)、信息技術設備(適用EN 60950-1)。
2. 核心安全要求
防護:基本絕緣/雙重絕緣設計(如爬電距離≥4mm)。
機械危險:運動部件防護(如離心機蓋聯鎖裝置)。
防火:非金屬材料阻燃等級(如V-1級)。
化學危害:泄漏液體防護(IP等級,如IP54)。
二、EN 61010-1儀器設備CE認證必備指令

三、EN 61010-1儀器設備CE認證流程
1. 準備階段
技術文檔:電路圖、PCB布局、關鍵元器件清單(需提供UL/VDE認證證據)。
樣品要求:至少2臺完整設備(含所有可選配置)。
2. 測試項目
電氣安全測試:
耐壓測試(1500V AC/1分鐘)
接地電阻測試(≤0.1Ω)
漏電流測試(≤0.5mA)
環境測試:
高溫運行(40℃持續4小時)
濕度測試(93%RH,48小時)
3. 后續義務
年度工廠審查(針對高風險設備)。
技術文件保存10年備查。

四、關鍵注意事項
1. 標志使用:
CE標志高度≥5mm,與公告機構編號并列(如CE 0123)。
2. 文檔語言:
技術文件需用歐盟官方語言(英語/目標國語言)。
3. 變更管理:
關鍵元器件更換(如電源模塊)需重新評估。
